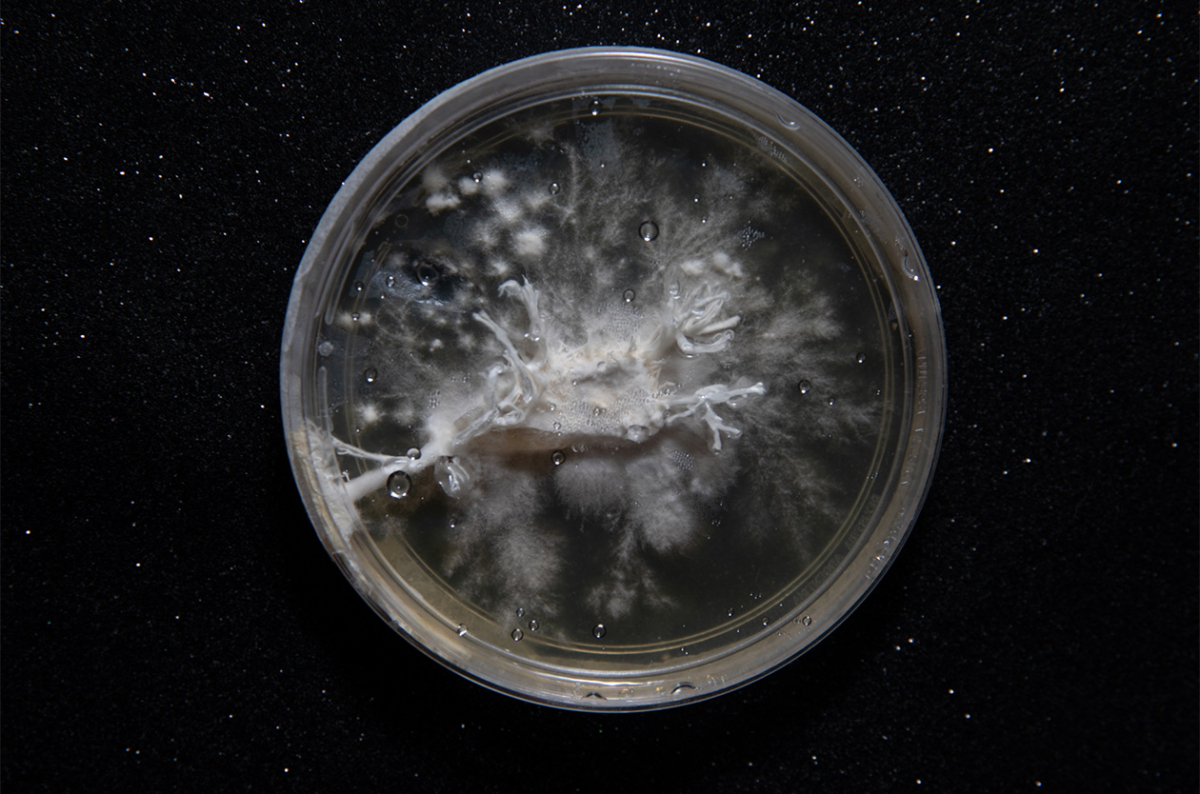

La psilocibina es el componente activo que les confiere el estatus de “mágicas” a más de 200 especies silvestres de hongos. Su uso se remonta a los pueblos originarios de México y América Central, pero hace tiempo que intenta cruzar el charco: del chamanismo al capitalismo, de la espiritualidad a la salud mental. Mientras la nueva ciencia de la psicodelia encuentra prometedores resultados y problemas epistemológicos en igual medida, las terapias que florecen en las napas se proponen estabilizar la vida anímica de una humanidad devastada.
“El cannabis oficia de punta de lanza para muchas alternativas terapéuticas —dice Antonio Catsigyanis, médico psiquiatra de la UBA, especializado en medicina cannábica que sigue con interés los hallazgos en torno a los psicodélicos—. La aceptación medicinal masiva de una sustancia otrora considerada peligrosa les abre la puerta a otras drogas que actúan en el cerebro como nuevos actores de la salud mental”. A diferencia del cannabis, el potencial terapéutico de los psicodélicos en el mundo occidental precede a su proliferación recreativa. Los científicos que lo estudiaron en los años 50 se entusiasmaron tanto con los efectos positivos que incentivaron el uso por fuera de sus laboratorios. La contracultura que los abrazó generó un pánico tal que para 1970 todos los ensayos clínicos habían sido desfinanciados y los psicodélicos fueron clasificados como las drogas más peligrosas del mundo.
A partir de la década del noventa un grupo de científicos y psicoterapeutas se propusieron recuperar y profundizar ese conocimiento a sottovoce, convencidos de que algo importante había quedado en el camino. Desde 2006 sus intuiciones intentan validarse desde la ciencia oficial. PubMed, una base de datos que reúne los principales estudios científicos relacionados con el campo de la salud, hoy arroja 1892 resultados para la palabra “psilocibina”. Los psicodélicos han regresado de forma contundente a la conversación científica y los sujetos rotos por una sociedad ultraliberal e individualista no pueden esperar el veredicto de la academia para abrazarlos como una alternativa terapéutica.
ocho gramos
Nicolás (32) está echado sobre la cama de un hotel de Palermo. La música que suena en sus auriculares lo guía y el antifaz lo protege de estímulos simples, que bajo el efecto de ocho gramos de hongos psilocibes serían excesivos. Nicolás está viajando mentalmente por las escenas más dolorosas de su vida, conducido por una entidad “superior”. Antes de contactar al psiquiatra que lo acompaña en la experiencia, llegó a tomar cinco fármacos a la vez. Atravesaba un cuadro de fobia social y depresión que había derivado en tres intentos de suicidio. No dormía, no quería levantarse a la mañana ni salir de su casa, y para cada síntoma le prescribieron una droga. “Hubo un momento en que sentí el cerebro frito —cuenta—. Me empezó a hacer mal al hígado y aumenté mucho de peso, pero lo peor es que no me sentía nada bien. Me hice adicto al clona y tuve que dejarlo. Llegué a tomarme una tableta de 2 miligramos por día. A veces las mezclaba con alcohol y estaba reventado, pero dormía como un zombie”.
Sobre su viaje motorizado por la psilocibina recuerda: “En esa subida llegué a un punto de sentirme conectado con todo. Me acuerdo algo muy puntual de ver un perro, una planta, un niño enfermo, un viejo, una piedra y sentir que yo era eso. No es que yo lo veía, no había una separación. Es difícil de explicar. Los problemas que tenía eran algo muy minúsculo en comparación al universo”.
Nicolás tuvo una experiencia mística. Puede sonar esotérica y de hecho lo es, pero lo curioso es que la línea tradicional de la investigación científica le adjudica tal relevancia que ha elaborado complejos cuestionarios para medirla. Sus principales características son la disolución momentánea del ego, la fusión del yo con el entorno que nos rodea, la sensación de que todo está conectado entre sí, la sensación de estar frente a una verdad revelada y de intenso bienestar.
“Hace quince años se empezaron a hacer estudios en humanos que mostraban que con una sola dosis de psilocibina de un psicodélico clásico se podían inducir estados alterados de conciencia de mucho significado personal y espiritual, y que esa experiencia se asociaba a beneficios psicosociales”, dice Aín Stolkiner, médico clínico y becario del CONICET. Se suman, vale aclararlo, estudios que han establecido correlatos neurocientíficos que lo explican desde un punto de vista biológico.

no fue magia
La psilocibina que se adhiere a los receptores de serotonina dispara en nuestro cerebro una sucesión caótica de impulsos eléctricos que produce nuevas conexiones entre las neuronas. Los psiquiatras que apoyan su uso sugieren que el aumento de la neuroplasticidad nos confiere la capacidad de cambiar con mayor facilidad comportamientos o modos de pensar, como la forma en la que percibimos al resto de las personas o a nosotros mismos. “Se cree que la depresión, la ansiedad, la adicción, los trastornos obsesivos compulsivos seguramente tengan que ver con una forma de pensar rutinaria que es muy difícil de modificar”, explica Stolkiner.
Estas nuevas conexiones tienden a desaparecer rápidamente: los pacientes consultados por crisis reportan una duración de la sensación aguda de bienestar de tres días a un mes. Pero el cerebro es un músculo que se entrena. Así como los patrones de pensamiento autorrefencial pueden solidificarse si se perpetúan en el tiempo provocando cuadros depresivos, la neuroplasticidad abrupta que producen los psicodélicos puede mantenerse si se la estimula con prácticas que tienen un efecto similar a nivel neuronal. Entre ellas, la meditación. “El día siguiente de la toma fue increíble —cuenta Nicolás—. Nunca me había sentido tan bien”. Por recomendación de su psiquiatra, se había preparado para la experiencia con prácticas de meditación que lo ayudaron a conectarse con esa sensación de bienestar cuando, luego del primer mes, los efectos comenzaron a diluirse. “Sigo sintiendo algunas de las cosas de antes, pero nunca con la misma intensidad. No volví a sentir ganas de matarme”.
Lo cierto es que no en todos los casos las terapias psicodélicas inducen experiencias místicas y, tal como ocurre con los fármacos antidepresivos, no siempre funcionan. “Como en cualquier terapia, no hay ninguna garantía”, dice Marina, psicóloga y desde hace casi dos años facilitadora de sesiones grupales de macrodosis de psilocibina. Junto a un colega armaron su protocolo basándose en el de instituciones estadounidenses como MAPS (Multidisciplinary Association for Psychedelic Studies), que recuperan lo que desde los años 60 se entiende como el set and setting. Es decir, la preparación previa del paciente y las condiciones en las que se realiza la experiencia: la privación sensorial, la presencia de dos terapeutas, la afabilidad del ambiente, la música sugestiva. “Te diría que más importante que tener o no una experiencia mística es la capacidad posterior de integrarla —aclara Marina—. Es importante que haya un marco. Que no quede como una droga suelta que produce psicodelia, sino que se la entienda como un estado alterado de conciencia que tiene la posibilidad de habilitar determinadas cuestiones propias que después pueden ser abordadas en un espacio terapéutico”, suma Catsigyanis.
¿cura o placebo?
En un estudio llevado a cabo por el Hospital Psiquiátrico de la Universidad de Zúrich se compararon los efectos de la psilocibina con los de un placebo en pacientes con depresión. Si bien los participantes de ambos grupos registraron una disminución de los síntomas a los catorce días, los del grupo expuesto a la psilocibina fueron considerablemente mayores (58% versus 16%).
Pero ganarle a un placebo es fácil, así que en 2018 un grupo de científicos del Imperial College de Londres compararon dos tomas de psilocibina con dosis diarias de escitalopram —un antidepresivo de primera línea— durante seis semanas. El estudio concluyó que, si bien ambos grupos presentaron una reducción de los síntomas, los efectos fueron de mayor magnitud y más rápidos en el grupo de la psilocibina.
En opinión del psiquiatra Catsigyanis, los efectos adversos son la principal causa de abandono de los tratamientos en la salud mental. En comparación con los antidepresivos, en el estudio se encontraron pocos y muy manejables, como leves molestias en la panza durante la toma o dolores de cabeza al día siguiente que desaparecieron rápidamente.
En 2022 se realizó un estudio de fase 2 (la anterior a la que habilita la comercialización de una droga en el mercado) con una muestra mucho más grande de participantes, donde se detectaron ideaciones suicidas como parte de los efectos adversos. Más allá de lo escandaloso de estos hallazgos no reportados antes, una vez más se encontró una gran reducción en los síntomas de depresión.
“La evidencia científica indica que a la larga esto podría funcionar —dice Enzo Tagliazucchi, físico especializado en neurociencia e investigador—. Sí existen algunos problemas puntuales en la investigación, pero no hay motivos para creer que estas dificultades no puedan ser superadas”.
El principal de ellos es entender el alcance del efecto placebo. Puede pasar que el que recibió el placebo piense que recibió psilocibina, pero es muy raro que suceda lo contrario y ahí es cuando empieza a jugar la expectativa. No obstante, Tagliazucchi agrega: “Estamos tratando de imitar el paradigma de investigación de drogas que no tienen efecto sobre la conciencia, como si fuera una aspirina. Quizás no es el modelo farmacológico el que hay que aplicar para validar su efectividad”.
Para decir que algo está probado en medicina hace falta, en definitiva, un gran volumen de estudios reiterados en diversas circunstancias y una disertación académica exhaustiva. Mientras estas discusiones alrededor de las dosis altas de psilocibina se desarrollan sobre una considerable cantidad de evidencia, existe otra alternativa que no ha esperado ningún tipo de aval para propagarse.
campo científico
En mayo de 2023, Azul (26) recibió su primer pack de microdosis: una latita con diez cápsulas grisáceas y un PDF con instrucciones. La microdosis consiste en la autoadministración de entre 0,1 y 0,2 gramos de hongos psilocibes bajo distintos protocolos. El más conocido es el de Fadiman, que propone una toma cada tres días, por un período de cuatro a ocho semanas, que puede repetirse luego de un descanso. Cuando Azul decidió ensayarlo por recomendación de su psicóloga, atravesaba una situación de acoso laboral que la tenía “echa una bola de estrés y ansiedad que me volvió disfuncional en mi accionar cotidiano”. Antes de incursionar con la psilocibina, Azul probó el camino de los fármacos durante cinco meses. “No era para mí —dice—. No me gustaba la idea de tapar los síntomas y fingir demencia. Además, el clonazepam me tenía tarada todo el día”.
“Todos los meses se me acercan al menos veinte personas”, dice Paula. No es médica ni psicóloga, estudió fitoterapia (el uso de productos vegetales con una finalidad terapéutica) y desde la pandemia comercializa cápsulas de psilocibina. “De principios de 2021 hasta hoy el crecimiento es exponencial, no solo de consultantes sino de personas que la ofrecen”. Algunos no realizan ningún tipo de seguimiento, otros lo hacen a través de grupos de WhatsApp, y también están los que ofrecen sesiones esporádicas de consultas, como es el caso de Paula. A ella se acercan personas de todas las edades: los veinteañeros mayormente lo hacen por curiosidad y los mayores de 60 por los hongos adaptógenos (especies no psicodélicas con cualidades medicinales). “Tengo algunos grandes que toman psilocibina, pero en general les cuesta más —dice Paula—. Ellos vienen de una generación de mucha pastilla, mucho sedante, donde toda incomodidad era tapada y muchas veces la psilocibina hace el efecto contrario”.
Los de la franja de 30 a 50 años son los que principalmente acuden por padecimientos de salud mental o para tratar temas puntuales como traumas o abusos, como Azul, que de a poco logró doblegar la ansiedad y la sensación de estar tomada por las emociones: “Encontré otro discernimiento. Sentía más claridad mental a la hora de atravesar las cosas y, en lugar de evadir, enfrentar la situación”. Pero también están quienes lo hacen para mejorar el foco y la creatividad, es decir, la ultraexigida productividad. “Su crecimiento exponencial se explica solo en parte por la supuesta rapidez y efectividad de sus resultados —dice Daniel Álvaro, doctor en Ciencias Sociales y en Filosofía—. Son técnicas de adaptación subjetiva a la realidad existente en la medida en que refuerzan el orden normativo, afectivo y racional en el que vivimos”.
“Hace un tiempo que me siento arriba de un cohete, hago las cosas con otra determinación —confirma Sebastián (45), quien hace dos años sigue el protocolo de Fadiman y en lo que va del 2023 ya lanzó dos discos solistas—. Cuando reducís la angustia y la preocupación, la creatividad viene sola”.
Reportes de casos como el de Azul y Sebastián existen de a montones. De hecho, un estudio publicado en junio de 2022 por la revista Scientific Reports realizó un seguimiento de los cambios en el estado de ánimo y la salud mental de 930 consumidores de microdosis versus 180 no consumidores durante un período de 30 días, encontrando pequeñas y medianas mejoras en los primeros. La observación se realizó sobre consumidores de un protocolo creado por el micólogo Paul Stamets —algo así como el padre occidental de los hongos—, que no solo propone una mayor intensidad (cuatro días de toma, dos días de descanso) sino también la combinación de la psilocibina con dos compuestos no psicoactivos: el hongo melena de león (Hericium erinaceus), del que se piensa que tiene incidencia en la neuroplasticidad; y una vitamina B3 llamada niacina, que tiene como propósito mejorar la absorción de los ingredientes activos y produce una intensa experiencia de calor y enrojecimiento momentáneo de la piel. El estudio no solo reportó mejoras en el ánimo de todos los participantes, sino que también reportó mejoras cognitivas en los adultos mayores.
El problema con esta publicación científica, además de llevar entre sus firmas la del creador del protocolo, es que abandona toda pretensión de aislar el efecto placebo o cualquier otra variable que pueda afectar positivamente. “Hasta ahora la evidencia que tenemos de la microdosis es anecdótica —dice el psiquiatra Catsigyanis—. Es decir, profesionales que encuentran mejoras en la esfera efectiva de los pacientes que deciden tomarlas”.
La ciencia ha encontrado mayores dificultades para probar los efectos positivos de la microdosis en estudios de situaciones controladas de laboratorio. En 2022, la revista Journal of Psychopharmacology publicó un estudio que concluía que la microdosis no afectaba el procesamiento de las emociones ni los síntomas de ansiedad y depresión en comparación con el placebo. En su laboratorio, Tagliazucchi llegó a la misma conclusión sobre la mejora objetiva en el foco y la creatividad en pacientes sanos, y al menos tres estudios más arrojan conclusiones similares. Sin embargo, una porción de la comunidad científica todavía considera que estas muestras son demasiado pequeñas y que atribuirle la totalidad de los efectos positivos a la expectativa es apresurado.

mercado farmacéutico
Una sesión cuesta alrededor de 100 dólares. Algunas se cobran en pesos y otras directamente en moneda extranjera. La mayoría se ofrece con sesiones de preparación previa e integración posterior que se cobran como una sesión psicoterapéutica estándar. “De los tratamientos que hice me pareció el más barato por lejos —dice Nicolás—. Porque la medicación psiquiátrica es carísima y las obras sociales te cubren apenas una parte”. Un pack de microdosis, en cambio, se consigue por 5 mil pesos. Son más baratas que la macrodosis no solo por su pesaje. Como no suponen una exposición emocional aguda, no requieren la presencia física de uno o dos profesionales durante al menos ocho horas. “Es el acompañamiento lo que vuelve todo más costoso —reflexiona Tagliazucchi—. Las farmacéuticas van a querer vender la mayor cantidad posible, imponiéndolas como una píldora mágica”. Stolkiner, en cambio, piensa que la industria no encuentra mucho negocio en la psicodelia: con el acompañamiento adecuado, la psilocibina podría lograr con dos tomas lo que los antidepresivos logran con una ingesta diaria de por lo menos un año.
Si bien las terapias psicodélicas pueden resultar restrictivas para ciertos segmentos —como toda la salud mental— y se espera el desembarco de farmacéuticas que sinteticen la droga y la vendan a precios irrisorios, el cultivo de hongos psiloscibes es tan sencillo que lo más probable es que coexistan un amplio abanico de precios y de grises legales. “A mí lo que me preocupa es que haya una proliferación de personas que no sean muy responsables —dice Tagliazucchi—. Porque una persona cuando toma psicódelicos está en una ventana de vulnerabilidad total. Ya ha habido algunos casos de denuncias de abuso”.
Más allá de las discusiones sobre su marco adecuado de tratamiento y el porqué de la efectividad en tal cantidad de casos reportados, la ciencia ha acordado sobre su seguridad toxicológica. “Actualmente no existe ninguna discusión académica seria sobre que los psicodélicos sean adictivos, generen un daño irreversible en el ADN o esas cosas que se dijeron en los años 70 —agrega Stolkiner—. Los riesgos de la psicolocibina no son desde el punto de vista físico sino por la exposición intensa que suponen”. Tagliazucchi se inclina por adaptar el campo científico a las experimentaciones autogestivas (colectivas o individuales) que van por fuera de ese campo: “Yo creo que va a llegar un momento en el cual su uso debería aprobarse aunque no entendamos exactamente cuánto mejores que el placebo son —dice—. Me parece que es algo casi humanitario permitir que las personas accedan a esto porque además ya está claro que lo van a hacer igual”.




